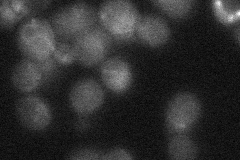
YPL087W
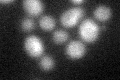
YPL087W

View description
Alkaline dihydroceramidase, involved in sphingolipid metabolism; preferentially hydrolyzes dihydroceramide to a free fatty acid and dihydrosphingosine; has a minor reverse activity
Localization:
Intensity:
Fold change:
Significance:
-
C’ GFP library in SD

below threshold14.37 -
N' NOP1pr-GFP in SD

ER56.001 -
N' TEF2pr-mCherry in SD

ER17.221 -
N' NATIVEpr-GFP in SD
below threshold22.7881 -
N' TEF2pr-VC and Cyto-VN in SD

below threshold21.6569 -
C’ GFP library in SD+DTT
cytosol15.471.07No -
C’ GFP library in SD+H2O2

cytosol14.090.98No -
C’ GFP library in Starvation Media

cytosol19.891.38No -
C’ GFP library on the background of Pup2-DaMP

N/A -
C’ GFP library on the background of CCT mutant

N/A0N/AYes
